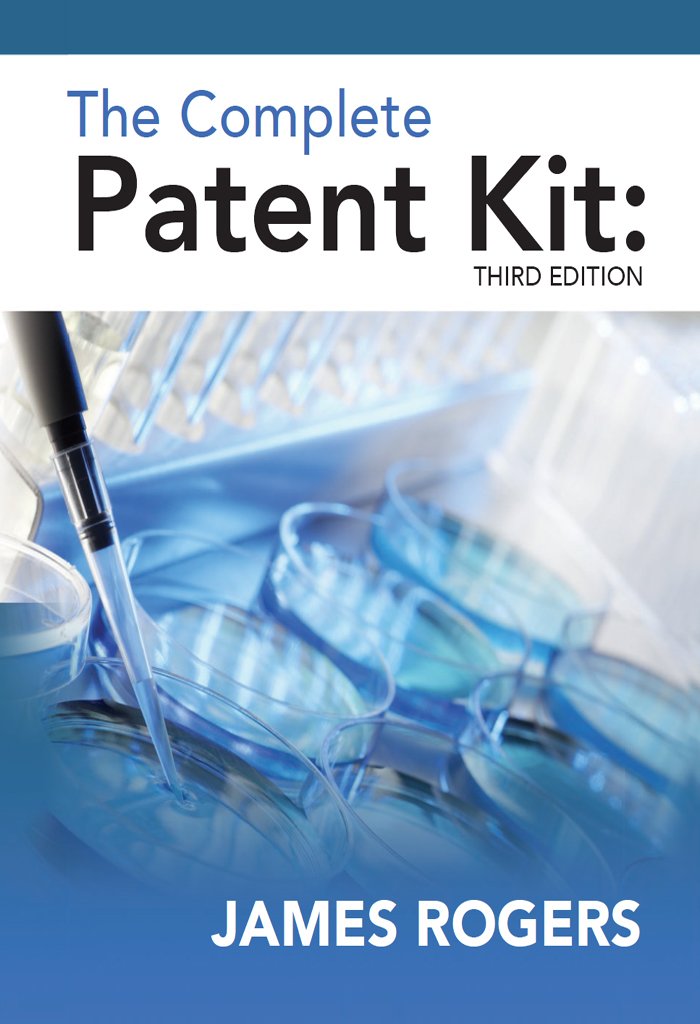
Amazon.com: The Complete Patent Kit: Third Edition eBook: James ... Amazon.com: The Complete Patent Kit: Third Edition eBook: James ...

The University of Florida College of Medicine is the medical school of the University of Florida. It is part of the J. Hillis Miller Health Science Center, with facilities in Gainesville and Jacksonville, Florida. The college grants the Doctor of Medicine (M.D.), Doctor of Medicine-Doctor of Philosophy (M.D.-Ph.D.), and Physician Assistant (P.A.) degrees to its graduates.

History
The college was officially established in 1956. The mission of the College of Medicine is to produce the next generation of specialists, scientists, clinical researchers, and health policy leaders. The college strives to improve health care in Florida, the United States, and the world through excellence and consistently superior leadership in education, clinical care, research, discovery, and service. The founding Dean of the college was Dr. George T. Harrell. Dr. Harrell also founded the College of Medicine at Pennsylvania State University, becoming the first person to found two medical schools.
In March 2009, the college received the largest donation in its history. Jerry and Judy Davis donated $20 million to the College of Medicine to support teaching, research and programs in cancer, with special emphasis on research in lymphoma, breast cancer, bone marrow and gastrointestinal cancer.
Uf College Of Medicine Video
Rankings
U.S. News and World Report ranked the College of Medicine 42nd out of 122 research-intensive medical schools in the U.S. in 2010.
The University's teaching hospital, Shands at the University of Florida, is nationally ranked in 7 specialties.
The ARWU ranked UF's College of Medicine 51st among schools of medicine across the globe in 2012.

Admissions
Admission to the University of Florida College of Medicine is considered to be highly competitive. For the M.D. class of 2015, 136 students were selected out of 2,853 applicants. The class' undergraduate average GPA was 3.75, while the average MCAT was 31.06. According to Dr. Gessner, former chair of the selection committee, the UF College of Medicine is a top choice for students if they want to receive a medical education in the state.

Deans of the College of Medicine
Are You Looking for Products
Here some products related to "University Of Florida College Of Medicine".
Don't Forget Remedy GOLD:..
The Complete Patent Kit: ..
Pathfinders of the Heart:..
The Ultimate Guide to Dry..
Get these at Amazon.com* amzn.to is official short URL for Amazon.com, provided by Bitly
Source of the article : here

EmoticonEmoticon